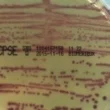

قياس السكر بعد الامتناع عن الطعام
يُعتبر فحص السكر بعد الامتناع عن الطعام (بالإنجليزية: Fasting blood sugar test) من الاختبارات الأساسية لتشخيص مرض السكري. يتم هذا الفحص بعد صيام الشخص لمدة تتراوح بين 8 إلى 12 ساعة، ويفضل إجراؤه في الصباح الباكر.
إذا كانت نتيجة الفحص أقل من 100 ملغ/ديسيلتر، يعتبر مستوى السكر في الدم طبيعيًا. أما إذا تراوحت النتيجة بين 100 و 125 ملغ/ديسيلتر، فهذا يشير إلى مرحلة ما قبل السكري. وإذا كانت النتيجة 126 ملغ/ديسيلتر أو أعلى، فقد يشير ذلك إلى احتمالية الإصابة بمرض السكري.
لتأكيد التشخيص، يجب تكرار الفحص في يوم آخر.
تقييم قدرة الجسم على التعامل مع الجلوكوز
يستخدم اختبار قدرة الجسم على تحمل الجلوكوز (بالإنجليزية: oral glucose tolerance test) لتقييم كيفية تعامل الجسم مع السكر. يتم هذا الاختبار عن طريق قياس مستوى السكر في الدم بعد صيام ليلة كاملة، ثم يتم إعطاء الشخص محلولاً سكرياً، وبعد ساعتين يتم قياس مستوى السكر مرة أخرى.
هذا الفحص يعتبر دقيقًا في تشخيص كل من مرحلة ما قبل السكري ومرض السكري نفسه.
تحليل نسبة السكر بصورة مفاجئة
فحص مستوى السكر بشكل عشوائي (بالإنجليزية: Random plasma glucose (RPG) test) لا يتطلب أي تحضير مسبق أو صيام. يمكن إجراء هذا الفحص في أي وقت من اليوم.
غالبًا ما يلجأ الأطباء إلى هذا الفحص عندما تظهر أعراض مرض السكري على الشخص ولا يرغبون في تأخير التشخيص.
معايرة الهيموغلوبين المرتبط بالجلوكوز
يحتوي الدم على خلايا الدم الحمراء (بالإنجليزية: Red Blood Cells) التي تحتوي بدورها على بروتين يسمى الهيموغلوبين (بالإنجليزية: Hemoglobin). يرتبط الهيموغلوبين بجزيئات الأكسجين وينقلها إلى جميع أنحاء الجسم.
يقوم اختبار الهيموغلوبين السكري (بالإنجليزية: Glycated hemoglobin (A1C) test) بقياس كمية السكر المرتبطة بالهيموغلوبين. هذا الفحص يعطي صورة واضحة عن متوسط مستوى السكر في الدم خلال الشهرين أو الثلاثة أشهر الماضية.
لا يتطلب هذا الفحص صيام الشخص قبل إجرائه.
قال رسول الله صلى الله عليه وسلم: “إنما الأعمال بالنيات، وإنما لكل امرئ ما نوى”. (متفق عليه)
قال تعالى: “وَقُلِ اعْمَلُوا فَسَيَرَى اللَّهُ عَمَلَكُمْ وَرَسُولُهُ وَالْمُؤْمِنُونَ ۖ وَسَتُرَدُّونَ إِلَىٰ عَالِمِ الْغَيْبِ وَالشَّهَادَةِ فَيُنَبِّئُكُم بِمَا كُنتُمْ تَعْمَلُونَ” (التوبة: 105).